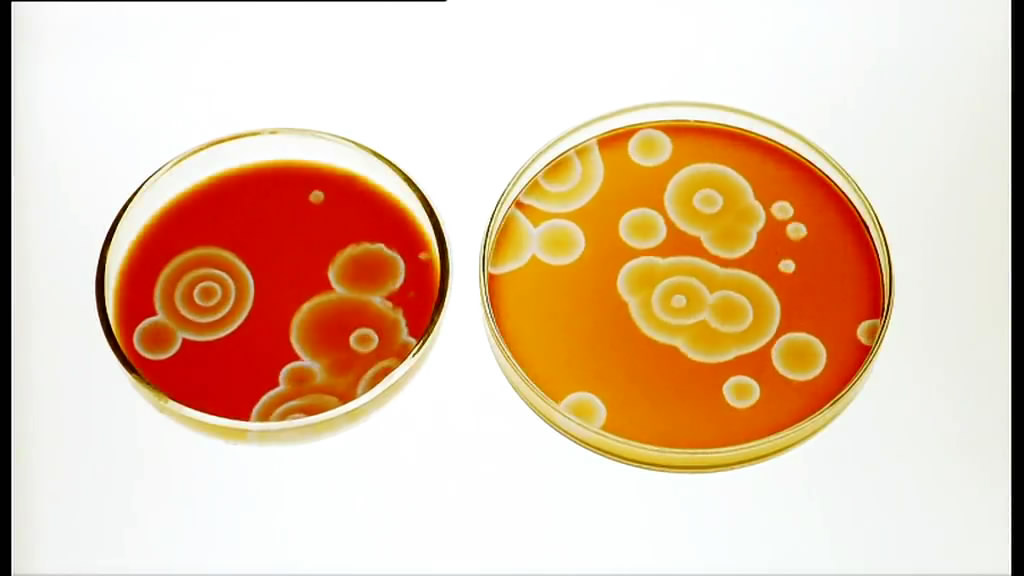
神秘的混沌理论(2010)的剧照 神秘的混沌理论(2010)的剧照

-
神秘的混沌理论(2010) 编辑
2010年Nic Stacey执导的电影
混沌理论,一直是困扰人类数千年的一个迷。这种在动态系统中无法用单一的数据关系解释和预测的神秘理论,在科学界只有初步的了解。在本部纪录片中,吉姆·奥卡利里教授将带领我们探索这神秘的混沌理论,试图揭开这层归因于神奇或者上帝力量的神秘面纱。
吉姆教授带着宇宙是如何由从尘埃中诞生,又是如何孕育出智慧生命的难题,开始了他的探秘旅程。混沌中的数学可以解释宇宙中从无序中产生有序的神奇景象,他揭示出大自然那些令人叹为观止的美丽和结构中隐藏的科学规律,它是物理定律的固有的组成。看过本片之后,你眼中的世界会变得与众不同。
吉姆教授带着宇宙是如何由从尘埃中诞生,又是如何孕育出智慧生命的难题,开始了他的探秘旅程。混沌中的数学可以解释宇宙中从无序中产生有序的神奇景象,他揭示出大自然那些令人叹为观止的美丽和结构中隐藏的科学规律,它是物理定律的固有的组成。看过本片之后,你眼中的世界会变得与众不同。